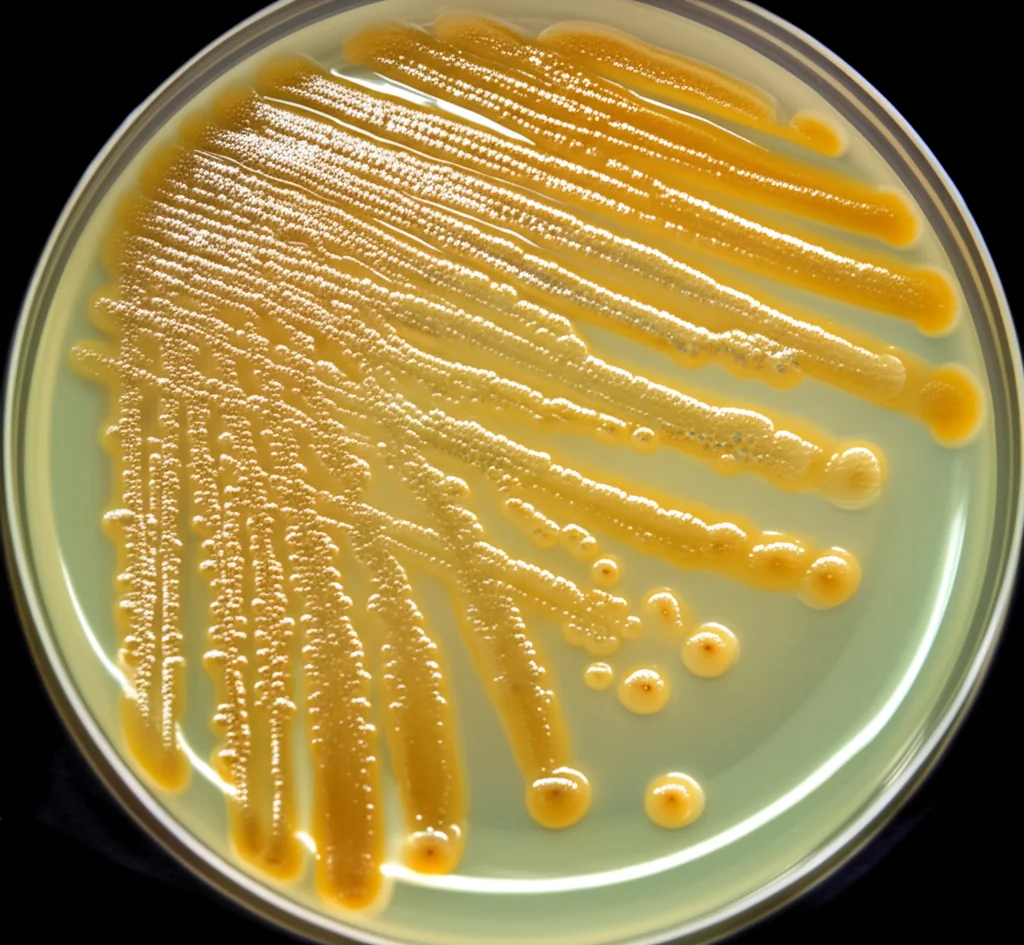
Immagine macrofotografica ad alta definizione di colonie batteriche di Staphylococcus aureus resistenti alla meticillina (MRSA) su una piastra di Petri, illuminazione controllata per evidenziare la struttura, obiettivo macro 100mm.

Resveratrolo in Nanocapsule Eco-Friendly: Una Nuova Speranza Contro l’MRSA?
Ciao a tutti! Oggi voglio parlarvi di una sfida che mi appassiona e che riguarda tutti noi: la lotta contro i superbatteri. Sapete, quei batteri tosti che se ne fregano degli antibiotici tradizionali? Uno dei più famosi (e temuti) è lo *Staphylococcus aureus* resistente alla meticillina, meglio noto come MRSA. Questo tipaccio è responsabile di infezioni davvero gravi e, purtroppo, sta diventando sempre più difficile da sconfiggere. Ma se vi dicessi che la natura, combinata con un pizzico di tecnologia futuristica, potrebbe darci una mano?
Il Nemico Pubblico Numero Uno: MRSA e la sua Corazza
Immaginate un batterio che non solo resiste a molti dei nostri farmaci più potenti, ma che è anche un maestro nel creare delle fortezze chiamate “biofilm”. L’MRSA è proprio così. Provoca un sacco di guai, da infezioni della pelle a polmoniti e setticemie, e la sua resistenza lo rende un vero incubo negli ospedali e non solo. I biofilm, poi, sono come città batteriche super protette, dove i batteri si nascondono e diventano ancora più resistenti agli antibiotici e al nostro sistema immunitario. Insomma, abbiamo un disperato bisogno di nuove strategie.
L’Idea Brillante: Natura + Nanotecnologia
E se la soluzione fosse già intorno a noi, magari in un bicchiere di vino rosso o in un mirtillo? Sto parlando del resveratrolo, una molecola naturale presente in uva, arachidi e frutti di bosco, famosa per le sue proprietà antiossidanti e antinfiammatorie. Ma c’è di più: il resveratrolo ha dimostrato di saper dare del filo da torcere anche ai batteri, MRSA incluso! Il problema? Il resveratrolo è un po’ timido: è poco solubile in acqua, non molto stabile e il nostro corpo lo elimina in fretta. Non proprio l’ideale per un farmaco.
Qui entra in gioco la nanotecnologia! Abbiamo pensato: e se “impacchettassimo” il resveratrolo in veicoli microscopici per proteggerlo e aiutarlo a raggiungere il bersaglio? Abbiamo scelto le nanocapsule lipidiche (LNC), delle sferette piccolissime (parliamo di nanometri, miliardesimi di metro!) fatte di grassi biocompatibili.
Ma non ci siamo fermati qui. Volevamo rendere il tutto ancora più “green” ed efficace. Abbiamo usato un metodo di preparazione chiamato “inversione di fase a temperatura” (PIT), che richiede poca energia e non usa solventi chimici dannosi. E abbiamo aggiunto un altro ingrediente naturale speciale: il linalolo, un componente di molti oli essenziali (come quello di lavanda), anch’esso con proprietà antibatteriche. La cosa furba è che il linalolo non è solo “caricato” dentro, ma fa proprio parte della struttura delle nostre nanocapsule (le abbiamo chiamate LIN-LNC). Infine, abbiamo caricato queste LIN-LNC con il nostro eroe, il resveratrolo (ottenendo le LIN-LNC-RES). Un concentrato di natura e tecnologia!
Missione MRSA: Le Nostre Nanocapsule all’Attacco!
Ebbene, come sono andate le nostre nanocapsule eco-friendly? I risultati sono stati davvero incoraggianti!
Caratteristiche da Formula 1: Le nostre LIN-LNC-RES si sono rivelate perfette: piccolissime (circa 35 nanometri), uniformi, con un’altissima capacità di incapsulare il resveratrolo (quasi il 98%!) e super stabili, mantenendo le loro proprietà per mesi se conservate in frigo. Inoltre, hanno dimostrato di rilasciare il resveratrolo in modo controllato nel tempo, come una sorta di “rilascio prolungato” a livello nanoscopico.
Potere Antibatterico Amplificato: Qui arriva il bello. Abbiamo testato le LIN-LNC-RES contro ceppi di *S. aureus* standard e, soprattutto, contro diversi ceppi clinici di MRSA super resistenti. Risultato? Le nanocapsule hanno avuto bisogno di una concentrazione fino a 4 volte inferiore di resveratrolo per bloccare la crescita dei batteri rispetto al resveratrolo “libero”. È come se avessimo reso il resveratrolo molto più potente ed efficiente! Anche le nanocapsule con solo linalolo (LIN-LNC) hanno mostrato un miglioramento rispetto al linalolo libero, ma l’accoppiata con il resveratrolo è stata la vera star.
Distruttori di Biofilm: E le fortezze batteriche? Le nostre LIN-LNC-RES si sono dimostrate delle vere demolitrici di biofilm. Non solo hanno impedito ai batteri MRSA di costruire i loro biofilm (con un’efficacia fino a 10 volte maggiore del resveratrolo libero in termini di concentrazione necessaria!), ma sono state anche capaci di attaccare e disgregare i biofilm già formati, molto meglio del resveratrolo da solo. Abbiamo persino “spiato” al microscopio elettronico (SEM): le immagini mostrano chiaramente come le LIN-LNC-RES devastino la struttura del biofilm e danneggino direttamente le membrane dei batteri, molto più efficacemente dei trattamenti singoli.
Come Funziona? Il Meccanismo Segreto
Ma come fanno queste nanocapsule a essere così efficaci? Sembra che agiscano su più fronti. Oltre al danno diretto alla membrana batterica, abbiamo scoperto che le LIN-LNC-RES riescono a “sabotare” i sistemi di comunicazione e di attacco dei batteri MRSA.
Abbiamo analizzato l’espressione di alcuni geni chiave per la virulenza dell’MRSA. In particolare, abbiamo visto che le nostre nanocapsule riducono significativamente l’espressione di un gene chiamato RNAIII. Questo gene è un po’ il “direttore d’orchestra” del sistema di quorum sensing dei batteri (il loro modo di “parlarsi” per coordinare gli attacchi) e regola molte delle loro “armi” (tossine, ecc.). Mettendo a tacere RNAIII, le LIN-LNC-RES rendono i batteri meno capaci di organizzarsi e di essere pericolosi.
Non solo: abbiamo visto che le nanocapsule interferiscono anche con un altro sistema di regolazione importante, chiamato SaeRS, che controlla altri fattori di virulenza e contribuisce alla formazione del biofilm. Insomma, le LIN-LNC-RES non si limitano a uccidere i batteri, ma li rendono anche meno “cattivi”.

Sicurezza ed Eco-Sostenibilità: Un Occhio al Futuro
Un aspetto fondamentale è la sicurezza. Abbiamo fatto dei test preliminari su cellule polmonari umane in coltura. I risultati suggeriscono che le nanocapsule “vuote” (Blank LNC) e quelle con linalolo (LIN-LNC) sono relativamente ben tollerate. L’aggiunta di resveratrolo (LIN-LNC-RES) aumenta la tossicità, ma questo è in parte atteso, dato che il resveratrolo è studiato anche come agente antitumorale. È importante sottolineare che questi sono test iniziali e serviranno studi più approfonditi, soprattutto in vivo, per confermare la sicurezza di questo approccio.
Tuttavia, il fatto di usare un metodo di produzione “verde” (PIT) e composti naturali come il resveratrolo e il linalolo rende questo approccio molto interessante dal punto di vista della sostenibilità ambientale, un tema sempre più cruciale.
Conclusioni (e Speranze)
Quindi, cosa ci portiamo a casa da questa ricerca? Abbiamo sviluppato un sistema nanotecnologico eco-friendly, basato su nanocapsule lipidiche contenenti linalolo e caricate con resveratrolo, che si è dimostrato molto promettente contro l’MRSA. Queste LIN-LNC-RES non solo hanno un’attività antibatterica potenziata, ma combattono anche i biofilm e riducono la virulenza dei batteri interferendo con i loro sistemi di regolazione genica.
Certo, la strada verso un’applicazione clinica è ancora lunga e richiede ulteriori studi (più ceppi batterici, test di sicurezza approfonditi, scalabilità della produzione), ma i risultati sono entusiasmanti. Ci dimostrano che combinare le risorse della natura con le potenzialità della nanotecnologia “verde” può davvero aprire nuove vie per affrontare una delle più grandi minacce per la salute globale: l’antibiotico-resistenza. È una piccola-grande speranza che arriva dal mondo dell’infinitamente piccolo!
Fonte: Springer
